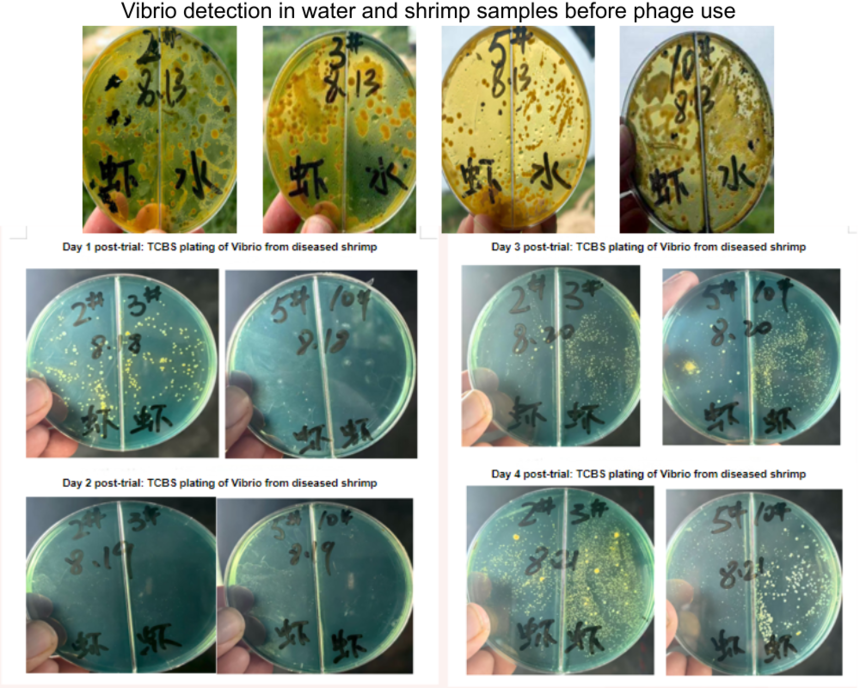
1763449510572638.png
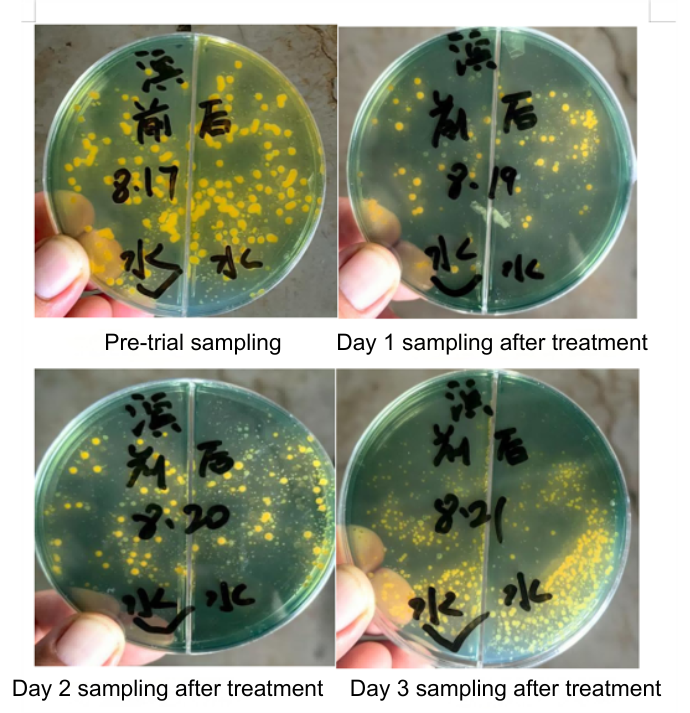
1763449790517405.png

|
Effective Vibrio Control in Aquaculture: A Case Study Review
Vibrio outbreaks remain one of the most significant threats to the profitability and sustainability of modern aquaculture. For shrimp and fish farmers, a sudden Vibriosis outbreak can mean catastrophic stock losses, reduced growth rates, and immense economic pressure. Traditionally, the industry has relied heavily on antibiotics, but with the rise of antibiotic-resistant bacteria and a growing global demand for sustainable food sources, these conventional methods are proving insufficient. Producers and distributors are increasingly asking a critical question: How can we effectively control Vibrio when our trusted tools no longer work? This article explores a powerful, natural alternative through the lens of real-world application. We will delve into five distinct case studies from commercial farms that were facing severe Vibrio challenges. These cases highlight a shift towards a more precise and sustainable method: bacteriophage therapy. The Growing Challenge of Vibriosis in Aquaculture
Vibriosis is a bacterial disease caused by species of the Vibrio genus, most notably Vibrio harveyi and Vibrio parahaemolyticus in marine aquaculture. These pathogens are opportunistic, thriving in intensive farming environments and causing devastating conditions like Acute Hepatopancreatic Necrosis Disease (AHPND). The economic impact is staggering. However, the true problem lies in the recurrence of infections. As one farm owner in Dongying, China, noted, "Conventional measures that used to suppress Vibrio quickly were no longer effective this year. We tried antimicrobial peptides, lysozyme, and even antibiotics, but the problem kept recurring." This cycle of infection, treatment, and reinfection highlights the urgent need for a solution that doesn't just treat symptoms but effectively manages the root cause—the pathogenic bacterial load in the water and the animals. Real-World Evidence: Field Case Studies in Phage Therapy
Bacteriophages are naturally occurring viruses that infect and kill only specific bacteria. They are harmless to shrimp, fish, humans, and the environment, making them an ideal biological control agent. The following case studies demonstrate their effectiveness in real-farm scenarios. Case 1: Combating a Stubborn V. harveyi Outbreak in a Whiteleg Shrimp Farm
Case 2: Proactive Vibrio Suppression with In-Feed Phage Application
o Day 1: Vibrio counts began to decrease. o Day 2: A significant drop in Vibrio levels was observed. o Day 3: Vibrio was no longer detectable in the sampled shrimp. o Insight: This trial also revealed that Vibrio counts began to rise again approximately two days after stopping treatment, highlighting the importance of continuous application for sustained control. Case 3: Rapid Water Quality Improvement at a High-Risk Farm
Case 4: Emergency Intervention in a Grouper Farm Catastrophe
o 24 hours: The client reported visible improvement in fish behavior. o 5 days: The fish had recovered, and the mass mortality event was resolved. o For prevention, the phage application was continued for an additional week to ensure the pathogen was fully suppressed. Key Takeaways: Best Practices for Phage ApplicationThese case studies collectively prove that bacteriophage therapy is a powerful tool for Vibrio control in aquaculture. The key takeaways for successful implementation are: 1. Versatility in Application: Phages are effective whether administered through feed to target intestinal bacteria or broadcast into the water to reduce environmental load. 2. Combined Approach Yields Best Results: Using both in-feed and water treatment methods, as seen in the shrimp and grouper cases, provides a comprehensive defense. 3. Consistency is Crucial: Vibrio is a persistent environmental challenge. The trials show that while phages work quickly, programmatic or continuous application is necessary to prevent the bacterial population from rebounding. Introducing a Targeted, High-Purity Phage Solution
The positive outcomes in these case studies were achieved using S-HU Powder (Vibrio Phage), a professional-grade phage cocktail. Developed with precision, S-HU Powder is a high-purity preparation (>10⁸ PFU/g) specifically targeting the most problematic pathogens: Vibrio harveyi and V. parahaemolyticus. Its ultrafiltered formulation minimizes carrier residues, ensuring it works swiftly to drive down Vibrio counts in both ponds and hatcheries. This enables a powerful antibiotic-sparing management strategy, paving the way for more sustainable and profitable aquaculture. |